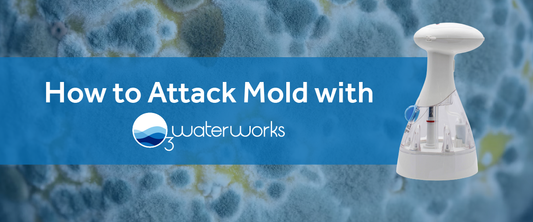

News

🌻🌻 Protect and Nourish Your Plants with O3 🌷🌷
We get a lot of questions from our customers about the best ways to use their o3waterworks Sanitizing Spray Bottle. One that keeps coming up is...
🌻🌻 Protect and Nourish Your Plants with O3 🌷🌷
We get a lot of questions from our customers about the best ways to use their o3waterworks Sanitizing Spray Bottle. One that keeps coming up is...
Got Mold? 🤢 We've Got You Covered
It is approaching mold season in the United States, as the summer and fall months tend to bring extra humidity to many parts of the country. Warm damp...
Got Mold? 🤢 We've Got You Covered
It is approaching mold season in the United States, as the summer and fall months tend to bring extra humidity to many parts of the country. Warm damp...

🌿 Spring Cleaning Just Got Easier and Cheaper! 🌼
One thing our planet does not need is MORE plastic. According to the United Nations, the amount of plastic produced each year weighs as much as every...
🌿 Spring Cleaning Just Got Easier and Cheaper! 🌼
One thing our planet does not need is MORE plastic. According to the United Nations, the amount of plastic produced each year weighs as much as every...

Don’t Be a Turkey, Clean While You Cook This Th...
Rest easy knowing that O3waterworks has made it easy to whip up your favorite family recipes this Turkey Day without that post cooking clean up anxiety. Our Sanitizing Spray Bottle...
Don’t Be a Turkey, Clean While You Cook This Th...
Rest easy knowing that O3waterworks has made it easy to whip up your favorite family recipes this Turkey Day without that post cooking clean up anxiety. Our Sanitizing Spray Bottle...

♻️ The Clean, Green, Hospitality Machine ♻️
The EnozoPro Commercial Sanitizing Spray Bottle by O3waterworks an environmentally safe replacement for traditional cleaners and sanitizers. Designed with your large, commercial space in mind with industrial-capacity sanitizing capabilities this bottle expands...
♻️ The Clean, Green, Hospitality Machine ♻️
The EnozoPro Commercial Sanitizing Spray Bottle by O3waterworks an environmentally safe replacement for traditional cleaners and sanitizers. Designed with your large, commercial space in mind with industrial-capacity sanitizing capabilities this bottle expands...



